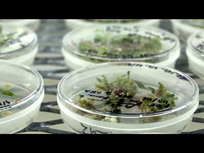

Plus des trois cinquièmes de la surface du globe terrestre sont recouverts d'eau, mais que savons-nous vraiment de cet élément ? L'eau aurait-t-elle une mémoire, comparable au disque dur d'un immense ordinateur, qui mémoriserait l'intégralité des données de la vie pour toujours ?